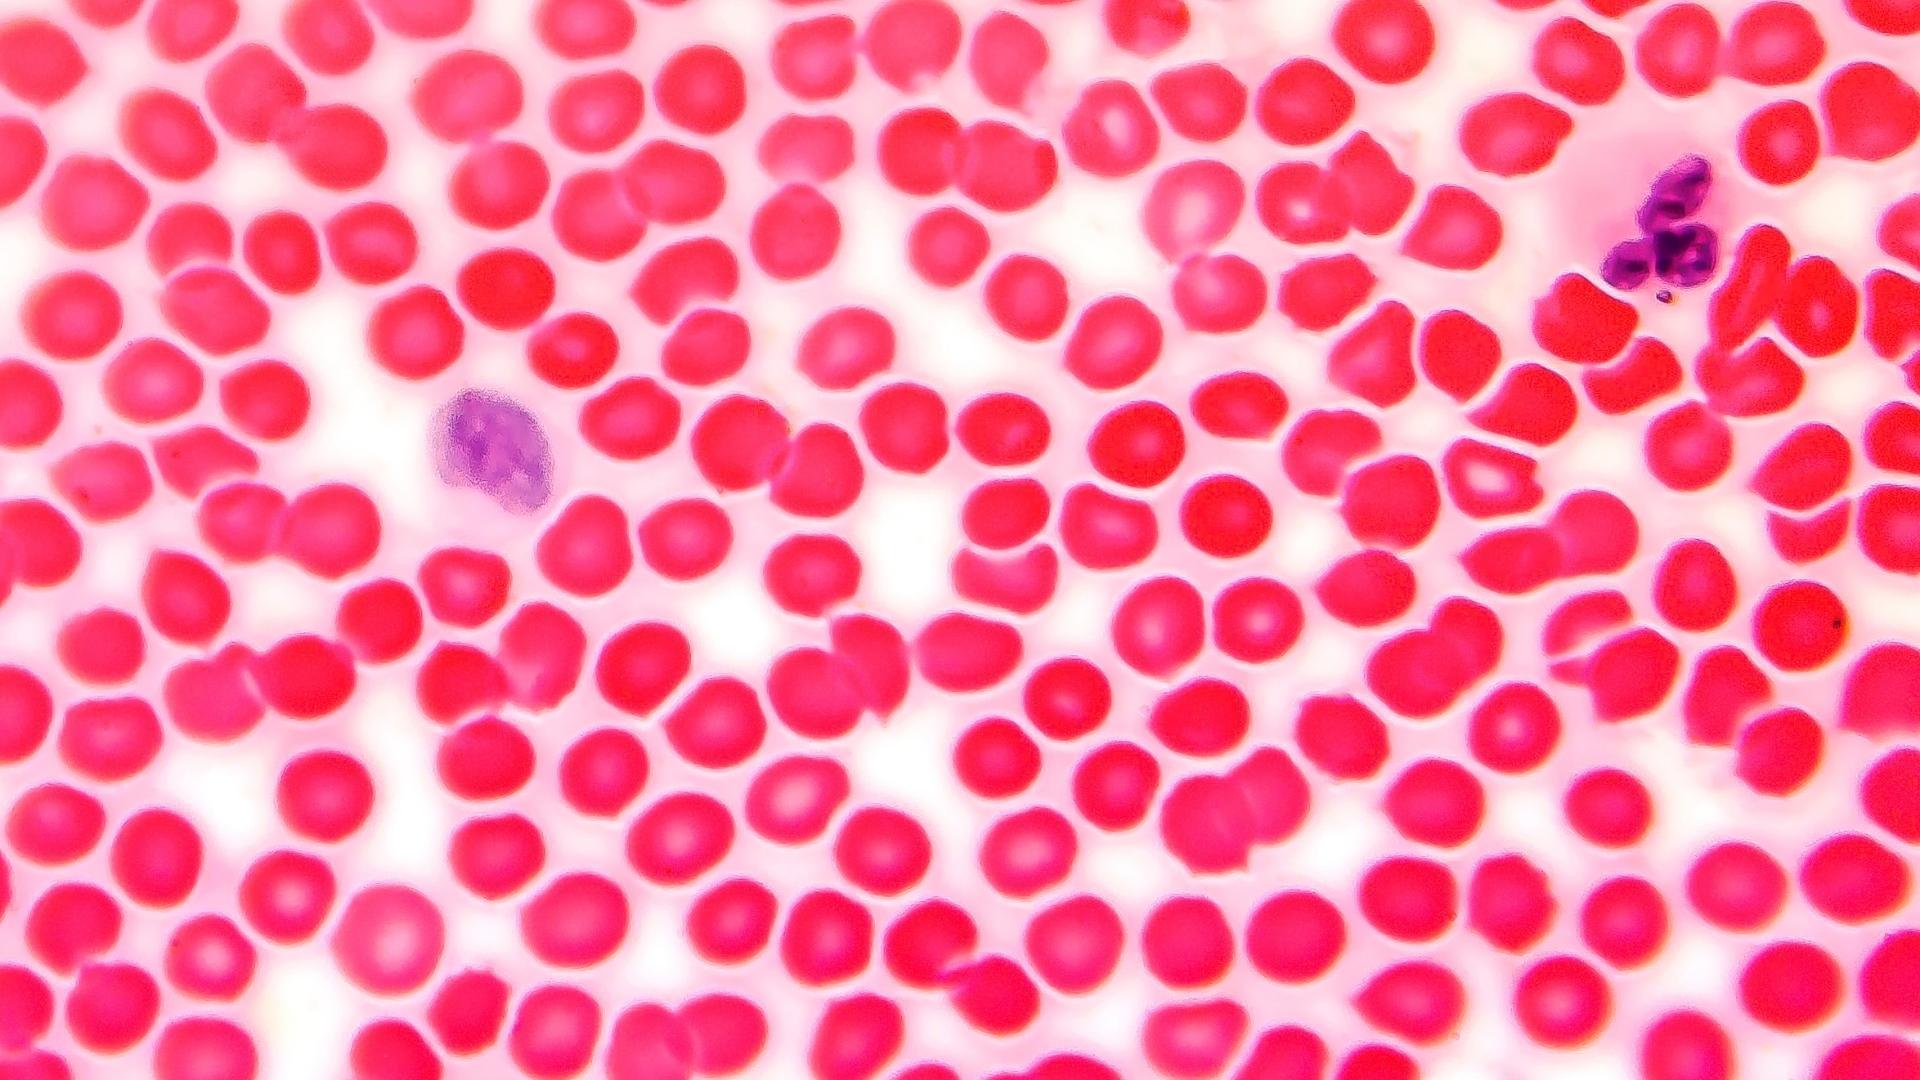

Кровь Животных Фото
Кровь Животных Фото 113 фото
День Богородицы 21 Сентября Картинки
Картинки С Днем Рождения Мужчине 29
Покраска На Темные Длинные Волосы Фото
Стояние Зои В Самаре Фото
Домашние Фото Брюнеток На Аву
Фото Розовых Обоев
Картинки С Днем Рождения Раскрашивать
Интерьер Узких Кухонь Фото
Золотые Смесители Для Ванной В Интерьере Фото
Кот И Дождь Картинки